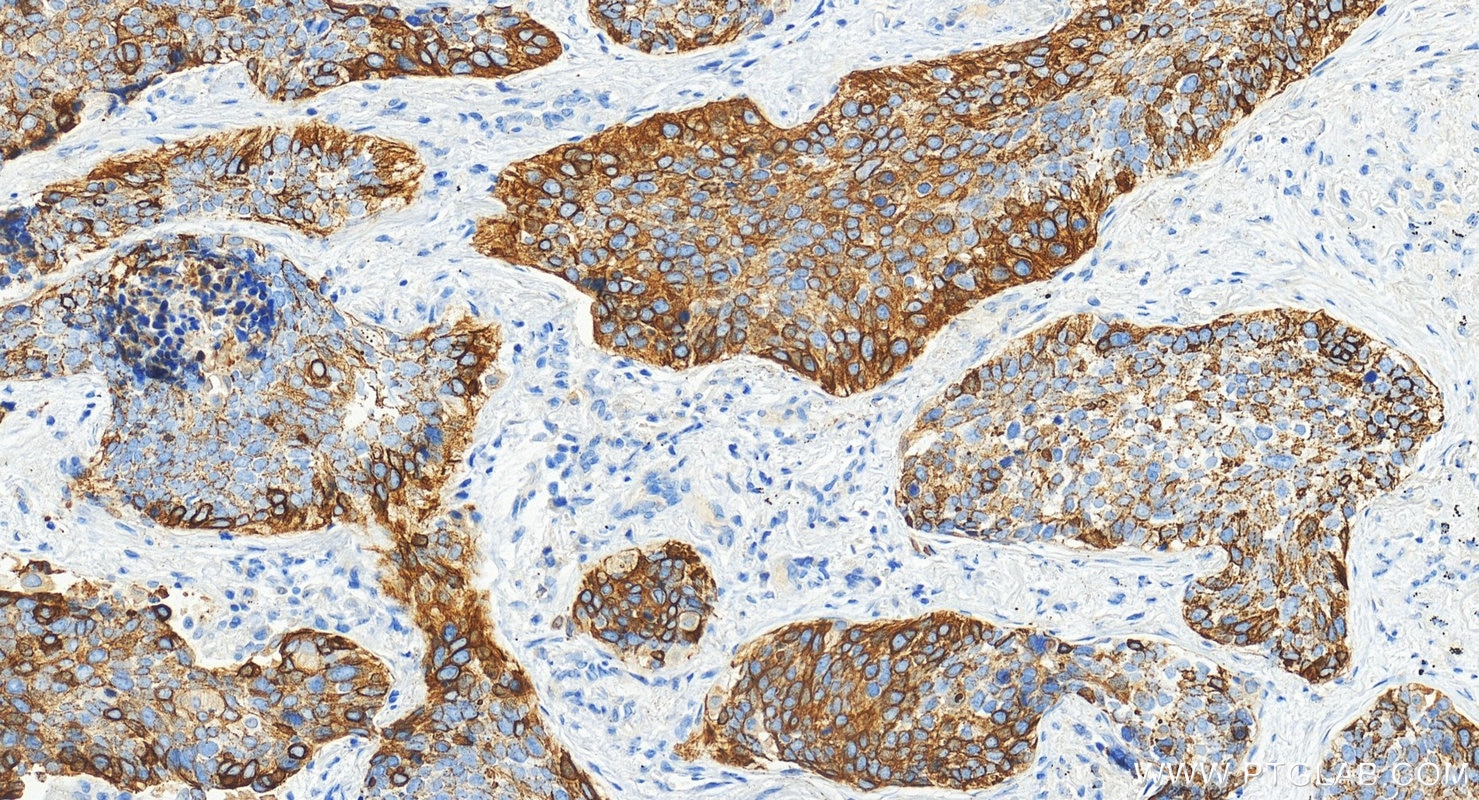
Immunohistochemical analysis of paraffin-embedded human lung squamous cell carcinoma tissue slide using 10143-1-AP (Cytokeratin 14 antibody) at dilution of 1:8000 (under 20x lens). Heat mediated antigen retrieval with Tris-EDTA buffer (pH 9.0). Immunohistochemistry (IHC) staining of human lung squamous cell carcinoma tissue using Cytokeratin 14 Polyclonal antibody (10143-1-AP)

Tested Applications
| Positive WB detected in | A431 cells, rat skin tissue |
| Positive IP detected in | A431 cells |
| Positive IHC detected in | human lung cancer tissue, human breast cancer tissue, human cervical cancer tissue, human lung squamous cell carcinoma tissue, human oesophagus cancer tissue, human skin tissue, human skin cancer tissue, mouse skin tissue, rat skin tissue Note: suggested antigen retrieval with TE buffer pH 9.0; (*) Alternatively, antigen retrieval may be performed with citrate buffer pH 6.0 |
| Positive IF/ICC detected in | HaCaT cells, HeLa cells, HepG2 cells |
| Positive FC (Intra) detected in | A431 cells |
Recommended dilution
| Application | Dilution |
|---|---|
| Western Blot (WB) | WB : 1:500-1:2000 |
| Immunoprecipitation (IP) | IP : 0.5-4.0 ug for 1.0-3.0 mg of total protein lysate |
| Immunohistochemistry (IHC) | IHC : 1:200-1:8000 |
| Immunofluorescence (IF)/ICC | IF/ICC : 1:200-1:800 |
| Flow Cytometry (FC) (INTRA) | FC (INTRA) : 0.40 ug per 10^6 cells in a 100 µl suspension |
| It is recommended that this reagent should be titrated in each testing system to obtain optimal results. | |
| Sample-dependent, Check data in validation data gallery. | |
Published Applications
| KD/KO | See 1 publications below |
| WB | See 21 publications below |
| IHC | See 27 publications below |
| IF | See 66 publications below |
Product Information
10143-1-AP targets Cytokeratin 14 in WB, IHC, IF/ICC, FC (Intra), IP, ELISA applications and shows reactivity with human, mouse, rat samples.
| Tested Reactivity | human, mouse, rat |
| Cited Reactivity | human, mouse, rat |
| Host / Isotype | Rabbit / IgG |
| Class | Polyclonal |
| Type | Antibody |
| Immunogen |
CatNo: Ag0188 Product name: Recombinant human KRT14 protein Source: e coli.-derived, PGEX-4T Tag: GST Domain: 262-472 aa of BC002690 Sequence: GQVGGDVNVEMDAAPGVDLSRILNEMRDQYEKMAEKNRKDAEEWFFTKTEELNREVATNSELVQSGKSEISELRRTMQNLEIELQSQLSMKASLENSLEETKGRYCMQLAQIQEMIGSVEEQLAQLRCEMEQQNQEYKILLDVKTRLEQEIATYRRLLEGEDAHLSSSQFSSGSQSSRDVTSSSRQIRTKVMDVHDGKVVSTHEQVLRTKN Predict reactive species |
| Full Name | keratin 14 |
| Calculated Molecular Weight | 472 aa, 52 kDa |
| Observed Molecular Weight | 47-50 kDa |
| GenBank Accession Number | BC002690 |
| Gene Symbol | Cytokeratin 14 |
| Gene ID (NCBI) | 3861 |
| RRID | AB_2134831 |
| Conjugate | Unconjugated |
| Form | Liquid |
| Purification Method | Antigen affinity purification |
| UNIPROT ID | P02533 |
| Storage Buffer | PBS with 0.02% sodium azide and 50% glycerol, pH 7.3. |
| Storage Conditions | Store at -20°C. Stable for one year after shipment. Aliquoting is unnecessary for -20oC storage. 20ul sizes contain 0.1% BSA. |
Background Information
Keratins are a large family of proteins that form the intermediate filament cytoskeleton of epithelial cells, which are classified into two major sequence types. Type I keratins are a group of acidic intermediate filament proteins, including K9-K23, and the hair keratins Ha1-Ha8. Type II keratins are the basic or neutral courterparts to the acidic type I keratins, including K1-K8, and the hair keratins, Hb1-Hb6. Keratin 14 is a type I cytokeratin. It is usually found as a heterotetramer with keratin 5. Keratins K14 and K5 have long been considered to be biochemical markers of the stratified squamous epithelia, including epidermis.
Protocols
| Product Specific Protocols | |
|---|---|
| FC protocol for Cytokeratin 14 antibody 10143-1-AP | Download protocol |
| IF protocol for Cytokeratin 14 antibody 10143-1-AP | Download protocol |
| IHC protocol for Cytokeratin 14 antibody 10143-1-AP | Download protocol |
| IP protocol for Cytokeratin 14 antibody 10143-1-AP | Download protocol |
| WB protocol for Cytokeratin 14 antibody 10143-1-AP | Download protocol |
| Standard Protocols | |
|---|---|
| Click here to view our Standard Protocols |
Publications
| Species | Application | Title |
|---|---|---|
Cell Stem Cell Injury Induces Endogenous Reprogramming and Dedifferentiation of Neuronal Progenitors to Multipotency. | ||
Bioact Mater Biomimetic gender-specific human skin model based on gonads/epidermis-on-a-chip | ||
Adv Sci (Weinh) Photothermal-Responsive Soluble Microneedle Patches for Meibomian Gland Dysfunction Therapy | ||
Nat Commun Malfunction of airway basal stem cells plays a crucial role in pathophysiology of tracheobronchopathia osteoplastica. | ||
Nat Commun Human induced pluripotent stem cell-derived vocal fold mucosa mimics development and responses to smoke exposure. | ||
Biomaterials MSC-derived exosomes protect against oxidative stress-induced skin injury via adaptive regulation of the NRF2 defense system. |
Reviews
The reviews below have been submitted by verified Proteintech customers who received an incentive for providing their feedback.
FH Nikolett (Verified Customer) (03-31-2026) | This antibody is ideal to human lung cancer tissue as a 1:100 dilution, utilized for IHC DAB staining with pH9 TE buffer.
|
FH Rachel (Verified Customer) (03-19-2024) | Excellent antibody, got the tester but will be purchasing more for future work.
![]() |
FH Parmveer (Verified Customer) (10-20-2019) | Worked well to detect basal cells around the prostate gland of formalin fixed tissue
![]() |
FH Joshua (Verified Customer) (05-10-2019) | Human Keratinocytes fixed in 4% paraformaldehyde and stained for KRT14. Goat anti-rabbit 488. Bright, specific staining observed.
![]() |